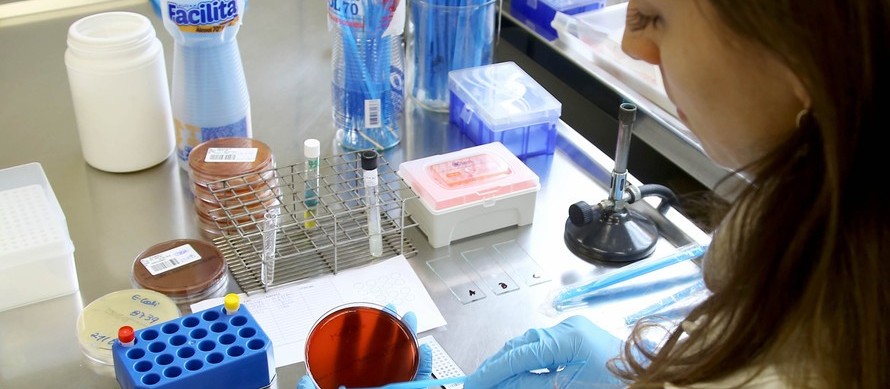

Acesse GMC Online
Para ver os dados do boletim anterior, dessa terça-feira (7), clique aqui
Quer enviar sugestão, comentário, foto ou vídeo para a CBN Maringá? Faça contato pelo WhatsApp (44) 99877 9550
Atualização
Maringá não registra óbitos por complicações da Covid-19 há três dias, segundo o boletim divulgado nesta quarta-feira, 8 de setembro, pela Secretaria Municipal de Saúde. Foram registrados 39 novos casos positivos da doença: 21 homens, 16 mulheres e duas crianças.
O boletim, que acompanha a evolução do coronavírus na cidade, foi divulgado às 15h18 desta quarta-feira pela Secretaria Municipal de Saúde, com dados coletados até às 23h59 dessa terça-feira (7).
O boletim mostra que Maringá soma 63.012 casos positivos de coronavírus desde o início da pandemia. Desses, 60.885 já estão recuperados, 601 são casos ativos (pacientes em isolamento domiciliar ou internados) e 1.526 morreram por complicações da doença.
Ocupação hospitalar
A taxa de ocupação hospitalar geral nos leitos de UTI adulto em unidades privadas de Maringá está em 53,52%, de acordo com a Secretaria Municipal de Saúde. Já a taxa de ocupação geral em leitos de UTI adulto no SUS está em 62,03% e nos leitos de UTI adulto exclusivos para Covid-19 está em 35,48%.
Veja mais detalhes do boletim do coronavírus desta quarta-feira, 8 de setembro, em Maringá:

Acesse GMC Online
Para ver os dados do boletim anterior, dessa terça-feira (7), clique aqui
Quer enviar sugestão, comentário, foto ou vídeo para a CBN Maringá? Faça contato pelo WhatsApp (44) 99877 9550
Notícias da mesma editoria
Respeitamos sua privacidade
Ao navegar neste site, você aceita os cookies que usamos para melhorar sua experiência. Conheça nossa Política de Privacidade
Editorias
Boletins
Institucional
Institucional